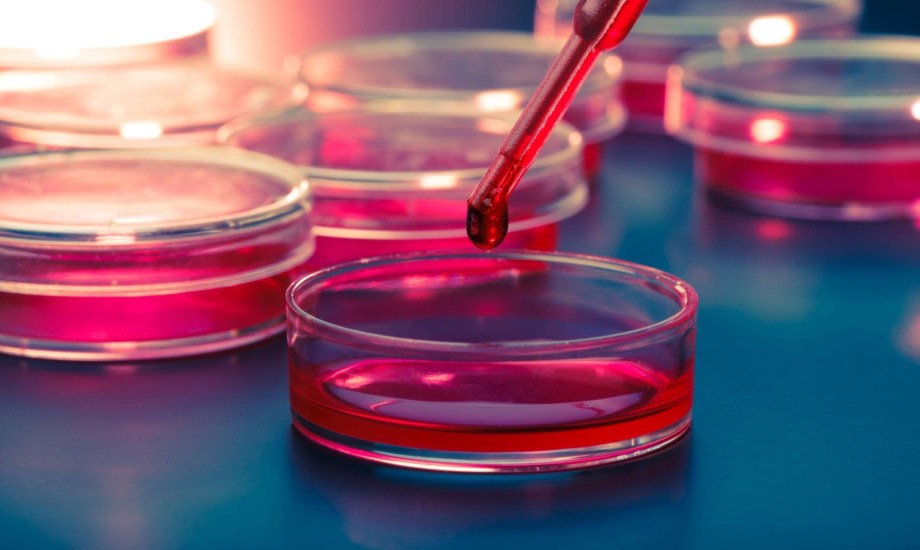
أفضل مستشفيات للعلاج بالخلايا الجذعية في الوطن العربي

أفضل 5 مستشفيات للعلاج بالخلايا الجذعية في الوطن العربي
هل سمعت من قبل عن العلاج بالخلايا الجذعية؟ يقول خبراء الطب إن هناك العديد من الفوائد التي يمكن الحصول عليها عند تطبيق العلاج بالخلايا الجذعية، بما في ذلك علاج مرض السكري والتصلب الجانبي وفشل القلب والالتهابات، وداء باركنسون، وغيرها من المشاكل الصحية.
وفي السطور التالية تستعرض "بوابة صحة" أفضل مراكز ومستشفيات متخصصة في العلاج بالخلايا الجذعية بالوطن العربي.
أفضل 5 مستشفيات للعلاج بالخلايا الجذعية في الوطن العربي
 تقدم دار الفؤاد خدمات طبية متعددة منها العلاج بالخلايا الجذعية
تقدم دار الفؤاد خدمات طبية متعددة منها العلاج بالخلايا الجذعية
1-مستشفى دار الفؤاد
يعد مستشفى دار الفؤاد -الحاصل على الاعتماد الدولي لجودة الرعاية الصحية- من المستشفيات الرائدة في مصر، حيث يقدم العديد من الخدمات الطبية النادرة بما في ذلك العلاج بالخلايا الجذعية، محققاً نتائج واعدة في ذلك.
2-مستشفى وادي النيل
إذا كنت تبحث عن مستشفى يقدم لك مختلف الخدمات الطبية بجودة عالية، فعليك باختيار مستشفى وادي النيل في مصر، حيث يمنحك جراحات متعددة مثل جراحة المخ والأعصاب، كما يتم الاعتماد على الطب النووي أيضاً، وبجانب ذلك، يوفر برامج متعلقة بالخلايا الجذعية التي تساهم في علاج بعض المشاكل الصحية.
3-مركز أبوظبي للخلايا الجذعية
يعد من المراكز الرائدة في الإمارات العربية المتحدة، كما أنه يقدم برامج علاجية متعددة تتضمن العلاج بالخلايا الجذعية، لذا إذا كنت تقضي فترة من الوقت في الإمارات العربية المتحدة كوجهة للسياحة العلاجية، يمكنك الحصول على الخدمات الطبية التي ترغب بها في مركز أبوظبي للخلايا الجذعية.
 مستشفى الملك فيصل متخصصة في مجال العلاج بالخلايا الجذعية
مستشفى الملك فيصل متخصصة في مجال العلاج بالخلايا الجذعية
4-مستشفى الملك فيصل التخصصي ومركز الأبحاث
إذا كنت تبحث عن مستشفى متطور في مجال العلاج بالخلايا الجذعية في السعودية، ينبغي الذهاب إلى مستشفى الملك فيصل التخصصي ومركز الأبحاث، فهو لا يقدم علاجات متنوعة في مجال زراعة الخلايا الجذعية فحسب، ولكنه أيضاً يعالج أمراض الدم.
5-مستشفى الملك المؤسس عبد الله الجامعي
مستشفى الملك المؤسس عبدالله الجامعي في الأردن يتمتع بأكثر من 20 سنة خبرة في تقديم الخدمات الصحيه ذات الجودة العالية، حيث يقدم 100% من الخدمة الآمنة عالية الجودة.